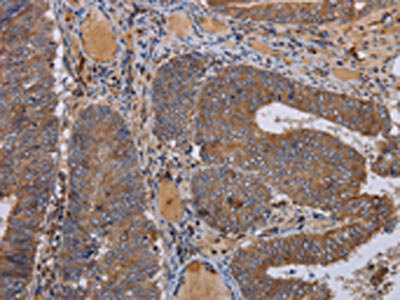

FADS1 Antibody
-
中文名稱:FADS1兔多克隆抗體
-
貨號:CSB-PA978301
-
規格:¥1100
-
圖片:
-
The image on the left is immunohistochemistry of paraffin-embedded Human colon cancer tissue using CSB-PA978301(FADS1 Antibody) at dilution 1/50, on the right is treated with fusion protein. (Original magnification: ×200)
-
The image on the left is immunohistochemistry of paraffin-embedded Human liver cancer tissue using CSB-PA978301(FADS1 Antibody) at dilution 1/50, on the right is treated with fusion protein. (Original magnification: ×200)
-
Gel: 8%SDS-PAGE, Lysate: 40 μg, Lane: Human fetal brain tissue, Primary antibody: CSB-PA978301(FADS1 Antibody) at dilution 1/300, Secondary antibody: Goat anti rabbit IgG at 1/8000 dilution, Exposure time: 2 minutes
-
-
其他:
產品詳情
-
Uniprot No.:
-
基因名:FADS1
-
別名:FADS1; FADSD5; Acyl-CoA; 8-3-desaturase; Delta(5 fatty acid desaturase; D5D; Delta(5 desaturase; Delta-5 desaturase; Fatty acid desaturase 1
-
宿主:Rabbit
-
反應種屬:Human,Mouse,Rat
-
免疫原:Fusion protein of Human FADS1
-
免疫原種屬:Homo sapiens (Human)
-
標記方式:Non-conjugated
-
抗體亞型:IgG
-
純化方式:Antigen affinity purification
-
濃度:It differs from different batches. Please contact us to confirm it.
-
保存緩沖液:-20°C, pH7.4 PBS, 0.05% NaN3, 40% Glycerol
-
產品提供形式:Liquid
-
應用范圍:ELISA,WB,IHC
-
推薦稀釋比:
Application Recommended Dilution ELISA 1:1000-1:2000 WB 1:200-1:1000 IHC 1:100-1:300 -
Protocols:
-
儲存條件:Upon receipt, store at -20°C or -80°C. Avoid repeated freeze.
-
貨期:Basically, we can dispatch the products out in 1-3 working days after receiving your orders. Delivery time maybe differs from different purchasing way or location, please kindly consult your local distributors for specific delivery time.
-
用途:For Research Use Only. Not for use in diagnostic or therapeutic procedures.
相關產品
靶點詳情
-
功能:Acts as a front-end fatty acyl-coenzyme A (CoA) desaturase that introduces a cis double bond at carbon 5 located between a preexisting double bond and the carboxyl end of the fatty acyl chain. Involved in biosynthesis of highly unsaturated fatty acids (HUFA) from the essential polyunsaturated fatty acids (PUFA) linoleic acid (LA) (18:2n-6) and alpha-linolenic acid (ALA) (18:3n-3) precursors. Specifically, desaturates dihomo-gamma-linoleoate (DGLA) (20:3n-6) and eicosatetraenoate (ETA) (20:4n-3) to generate arachidonate (AA) (20:4n-6) and eicosapentaenoate (EPA) (20:5n-3), respectively. As a rate limiting enzyme for DGLA (20:3n-6) and AA (20:4n-6)-derived eicosanoid biosynthesis, controls the metabolism of inflammatory lipids like prostaglandin E2, critical for efficient acute inflammatory response and maintenance of epithelium homeostasis. Contributes to membrane phospholipid biosynthesis by providing AA (20:4n-6) as a major acyl chain esterified into phospholipids. In particular, regulates phosphatidylinositol-4,5-bisphosphate levels, modulating inflammatory cytokine production in T-cells. Also desaturates (11E)-octadecenoate (trans-vaccenoate)(18:1n-9), a metabolite in the biohydrogenation pathway of LA (18:2n-6).; Does not exhibit any catalytic activity toward 20:3n-6, but it may enhance FADS2 activity.
-
基因功能參考文獻:
- FADS1 role in the oleic acid metabolism PMID: 29413358
- review identified that FADS polymorphism may alter plasma fatty acid composition and play a protective role in the development of type 2 diabetes PMID: 29899246
- FADS1/2 SNPs affect dietary fatty acid metabolism in centrally obese postmenopausal Polish women. PMID: 30103441
- The results of this population-based study provide evidence for a relationship between lipid regulatory gene polymorphisms including GCKR (rs780094), GCKR (rs1260333), FADS (rs174547), and MLXIPL (rs3812316) with dyslipidemia in an Iranian population. PMID: 29858861
- An association was found between the rs174550 FADS1 polymorphism and gestational diabetes mellitus risk. PMID: 28359772
- commonly overexpressed COX in cancer (~90% of colon cancer patients) can be taken advantage to suppress cell growth by knocking down delta-5-desaturase (D5D, a key enzyme that converts DGLA to arachidonic acid). In addition, D5D knockdown along with DGLA supplement may enhance the efficacy of chemotherapeutic drugs PMID: 27101738
- In minor allele carriers of FADS1 and FADS2, plasma arachidonic acid (ARA) content was elevated only at the highest level of ARA consumed in infant formula. ARA level in plasma is reduced by low ARA consumption and by minor alleles in FADS in infants fed ARA-containing formula. PMID: 27276431
- D5D knockdown in conjunction with dihomo-gamma-linolenic acid treatment can also be used to inhibit growth of pancreatic cancer cells via p53 independent pathway. PMID: 27368132
- Our results showed that knockdown of delta-5-desaturase along with DGLA supplement not only significantly inhibited cell migration, but also improved the efficacies of 5-flurouracil and gemcitabine, two frontline chemotherapy drugs currently used in the treatment of colon and pancreatic cancer. PMID: 28157665
- The majority of CpG sites (117 out of 136, 86%) exhibited high levels of methylation with the greatest variability observed at three key regulatory regions-the promoter regions for FADS1 and FADS2 and a putative enhancer site between the two genes. PMID: 28957329
- FADS1 rs174547 and FADS2 rs2727270 genotypes were significantly correlated with decreased HDL-C concentrations, and D5D /D6D activities as estimated as 20:4(n-6)/20:3 (n-6) and 18:3 (n-6)/18:2 (n-6) in a linear pattern in patients with type 2 diabetes PMID: 28555039
- Results indicate that genetic variation in the FADS1 gene, rs174546, influences blood pressure via arachidonic acid and body mass index. Thus, polymorphisms with an impact on the delta-5 desaturase activity may play a role for the blood pressure level mediated through polyunsaturated fatty acids and body mass index. PMID: 28732058
- FADS1 rs174549 polymorphism and fish consumption may be protective factors for oral cancer, with a gene-diet multiplicative interaction PMID: 28178666
- The derived allele of rs174557, which is the common variant in most populations, diminishes binding of PATZ1, a transcription factor conferring allele-specific downregulation of FADS1. PMID: 27932482
- a 2-locus constructed haplotype (rs174547-rs174553) affected gamma-linoleic acid and arachidonic acid concentration in breast milk of Chinese women PMID: 27269715
- This study showed associations between FADS 1/2 SNPs and cognitive performance. rs1535 minor allele homozygosity and rs174448 major allele carriage associated with improved cognitive performance in 8- to 11-y-old boys but not in girls, thereby counteracting existing sex differences. PMID: 28515069
- we determined rs66698963 genotype frequencies from 234 individuals of a primarily vegetarian Indian population and 311 individuals from the US. A much higher I/I genotype frequency was found in Indians (68%) than in the US (18%). A much higher I/I genotype frequency was found in Indians (68%) than in the US (18%). A global I/I genotype of 70% in South Asians, 53% in Africans, 29% in East Asians, and 17% in Europeans PMID: 27188529
- An association of FADS1 rs174547 with the fatty acid composition of plasma phospholipids was identified among this Chinese adult population. PMID: 28359317
- rs174549 polymorphism is favorable factor in predicting oral cancer progression-free survival in response to chemoradiotherapy PMID: 27542551
- the single nucleotide polymorphism rs174547 (T/C) of the fatty acid desaturase-1 gene, FADS1, is associated with changes in arachidonic acid compositions of the blood of elderly Japanese PMID: 26869086
- Our results demonstrate that FADS1-FADS2 are susceptibility genes for PCOS. PMID: 26879377
- FADS1 rs174546 single nucleotide polymorphism correlation with fatty acids profiles in blood PMID: 26346302
- Single nucleotide polymorphisms in FADS gene (particularly rs174537) associate with plasma fatty acids and desaturase levels in patients with both type 2 diabetes and coronary artery disease. PMID: 27004414
- FADS1 variants modulate the relationship between marine fatty acid intake and circulating levels of long-chain omega-3 fatty acids. PMID: 26501394
- No associations were observed between any single-nucleotide polymorphisms and major depressive disorder diagnosis or attempted suicide status. PMID: 26513616
- polymorphisms in the FADS gene cluster were nominally associated with reduced risk of developing atopic eczema PMID: 26633493
- genetic association study in population of pregnant women in Republic of Seychelles: SNPs in FADS1/FADS2 are associated with maternal arachidonic acid status; a subtle association exists with neurodevelopment in this high fish-eating population. [REVIEW] PMID: 26474818
- Suggest that the FADS1 rs174546 SNP and the FADS2 rs174601 SNP are associated with the risk of coronary artery disease and ischemic stroke, and are likely to influence serum lipid levels. PMID: 26261632
- genome-wide association study in population of mother/infant dyads in Denmark: Data suggest SNPs in maternal FADS1 are associated with (1) lower breast milk polyunsaturated fatty acid and (2) higher production of interleukins by infant T-lymphocytes. PMID: 26283408
- Dietary fatty acids modulate associations between FADS1 genetic variants and circulating fatty acids in plasma and erythrocyte membranes. PMID: 25626431
- Decreased Expression of FADS1 is associated with Esophageal Squamous Cell Carcinoma. PMID: 26163647
- High dietary n-3 LCPUFA intakes could negate the unfavorable effect of genetic variation in FADS1 on CAD in middle-aged and elderly Chinese population. PMID: 25849351
- Data suggest that down-regulation of FADS1 (delta-5 fatty acid desaturase) and up-regulation of FADS2 (delta-6 fatty acid desaturase) in obesity leads to altered long-chain polyunsaturated fatty acid nutritional status. [META-ANALYSIS, REVIEW] PMID: 25828602
- In northern Han Chinese people, the minor allele (T) of rs174616 in the FADS1-FADS2 gene cluster is associated with a decreased conversion rate of Linoleic acid to Arachidonic acid, which may contribute to decreased reduced risk of developing T2 diabetes. PMID: 25981324
- Study shows that docosahexaenoic acid (DHA) and arachidonic acid (ARA) levels were lower in pregnant women homozygous for FADS1 rs174533 but after DHA supplementation, ARA level decreases in women homozygous for both FADS1rs174533 and FADS2rs1747575. PMID: 25500337
- Fads1 and Fads2 gene expression was reduced by EPA and AA, but not ALA or LA PMID: 25755223
- rare alleles of SNPs significantly associated with the accumulation of multiple long-chain fatty acids in the liver PMID: 25123259
- examined the impact of a highly influential FADS SNP, rs174537 on leukotriene, HETE, prostaglandin, and thromboxane biosynthesis in stimulated whole blood PMID: 24962583
- genetic association study in population of children in Denmark: Data suggest that SNPs in FADS1 (rs1535, rs174448, rs174575) are associated with developmental psychomotor disorders at 30 months of age. PMID: 25080457
- Minor allele homozygotes and heterozygotes of rs174575 and rs174537 had lower PL 20:4 omega-6 levels in healthy individuals. PMID: 24985009
- maternal rs174556 FADS SNP modified the associations of maternal docosahexaenoic acid (DHA) intake in pregnancy with pregnancy duration and child birth weight PMID: 24991040
- These results suggest that genetic variation at the FADS locus can influence an individual's response to fish oil supplements. PMID: 24936800
- we found weak, but not convincing, evidence of effect modification by genetic variation in FADS1 on the associations between polyunsaturated fatty acid intakes and cardiovascular disease risk. PMID: 25008580
- Recent genome-wide association studies showed that FADS1/FADS2 genetic locus, beyond being the main determinant of PUFA, was strongly associated with plasma lipids and glucose metabolism. PMID: 25038994
- ALA intake was significantly more protective for IA in the presence of an increasing number of minor alleles at FADS1 PMID: 24240437
- Single-nucleotide polymorphisms in the FADS1 gene is associated with lower arachidonic acid concentrations in the colon. PMID: 24022589
- Changes in the mRNA-expression levels of FADS1 and 2 directly affect blood DGLA levels and D6D activity. This study suggests that lower mRNA-expressions of FADS2 and ELOVL5 are associated with higher risk of atopic eczema in young children. PMID: 24167612
- Weak evidence suggests that SNPs in FADS1/2 may influence high sensitivity C-reactive protein levels in young adults. PMID: 23867726
- We conclude that FADS2 genotype may play a role in peroxidation susceptibility of lipoproteins PMID: 23721366
- These data suggested that FADS1 genetic variant was associated with circulating PUFA and lipid levels and that its effect on HDL cholesterol might depend on PUFA status in the Han Chinese population. PMID: 23396965
顯示更多
收起更多
-
亞細胞定位:[Isoform 1]: Endoplasmic reticulum membrane; Multi-pass membrane protein. Mitochondrion.; [Isoform 2]: Endoplasmic reticulum membrane; Multi-pass membrane protein.
-
蛋白家族:Fatty acid desaturase type 1 family
-
組織特異性:Widely expressed, with highest levels in liver, brain, adrenal gland and heart. Highly expressed in fetal liver and brain.
-
數據庫鏈接:
Most popular with customers
-
-
YWHAB Recombinant Monoclonal Antibody
Applications: ELISA, WB, IHC, IF, FC
Species Reactivity: Human, Mouse, Rat
-
Phospho-YAP1 (S127) Recombinant Monoclonal Antibody
Applications: ELISA, WB, IHC
Species Reactivity: Human
-
-
-
-
-